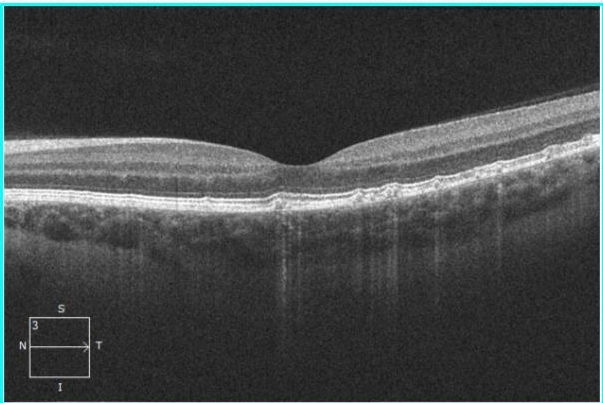
Доминантные друзы мембраны Бруха

Впервые гистологическая картина друз представлена С. Wedl в 1854 г., и чуть позже их клинику описал F. C. Donders (1855). Позднее в литературе доминантные наследственные друзы сетчатки встречались под множеством названий: «хороидит Хатчинсона-Тая» , «фамильный хороидит», «хороидит Гуттата», «поверхностный хороиретинит Холсоуса-Баттена», «кристаллиновая ретинальная дегенерация», «гиалиновая дистрофия», «сотовидная дегенерация Дойне», «Левентинская болезнь» и др.
Сходство происхождения и гистологические находки свидетельствуют о том что это — одно и то же заболевание. L.G. Hyman и соавт. (1983) на основании результатов обследования пациентов с друзами и старческой макулодистрофией пришли к заключению, что существует достоверная связь между наследственными друзами и развитием возрастной макулодистрофии
Термин «доминантные друзы» может быть использован только в тех случаях, когда они наблюдаются у членов одной семьи и достоверно подтверждаются при обнаружении их у лиц в относительно раннем возрасте, что указывает на наследственную природу друз, наследуемых по аутосомно-доминантному типу. Обычно они проявляются в возрасте 20-30 лет, но описаны случаи их возникновения и в 8-12 лет. Однако вариабельность экспрессии и неполная пенетрантность гена служили основанием для генетических ошибок при постановке диагноза.
Друзы мембраны Бруха не следует отождествлять с друзами диска зрительного нерва. По мнению некоторых исследователей, эти офтальмоскопически сходные образования различаются по структуре, что выявлено в гистологических исследованиях. В то же время различий между наследственными друзами мембраны Бруха и друзами, видимыми офтальмоскопически при сенильной макулодистрофии, отмечено не было, что было подтверждено при гистологических, микроскопических и ультраструктурных исследованиях. В связи с этим в настоящее время наследственные друзы рассматривают как начальную стадию связанной с возрастом дистрофии макулярной области, ранее называвшуюся сенильной макулодистрофией.
J. Gass (1977) отмечал, что у пациентов с фамильными друзами имеется одно и то же наследственно-дегенеративное заболевание глаз, которое нередко является причиной снижения зрения на шестой и седьмой декаде жизни. В связи с различной экспрессией гена и его неполной пенетрантностью иногда трудно точно определить число заболевших в одной семье. На основании результатов многочисленных исследований пациентов 50 лет и старше было установлено, что частота выявления друз увеличивается с возрастом и они несколько чаще встречаются у мужчин.
Патогенез
По данным А.Е. Krill (1972), существуют три теории происхождения друз.
- В первой — трансформационной — образование друз рассматривается как непосредственная трансформация клеток пигментного эпителия.
- Во второй — депозитной или секреторной теории — предполагается, что друзы образуются в результате секреции и отложений аномальных клеток пигментного эпителия.
- Третья теория — хороиваскулярная: предполагается, что друзы — это продукт гиалиновой дегенерации хороикапилляров или организация хороикапиллярных кровоизлияний. Однако хороиваскулярная теория источника друз не нашла гистологических подтверждений.
Гистологические исследования друз показали, что они состоят из двух основных компонентов: мукополисахаридного (сиаломуцина) и липидного — цереброзида. Считается, что эти субстанции образуются в дегенеративно измененном пигментном эпителии. Друзы, которые располагаются во внутренней порции мембраны Бруха, прилежат к пигментному эпителию и формируются в результате его аутофагальной деструкции, связанной с аномальной лизосомальной активностью. По мере развития процесса большое количество лизосом в клетках пигментного эпителия, очевидно, превращается в аморфноподобный материал, заполняющий внутреннюю коллагеновую зону мембраны Бруха. Размеры друз варьируют, они могут кальцифиироваться. Пигментный эпителий сетчатки, покрывающий друзы претерпевает ряд изменений.
Вначале в его цитоплазме происходит рассеивание пигмента, сопровождающееся дегенерацией митохондрий и смещением ядра. В конечной стадии дегенерированные клетки пигментного эпителия сливаются с друзами, в результате чего образуются участки на которых отсутствует пигментный эпителий. Фоторецепторы смещаются и подвергаются дистрофическим изменениям. Образование друз в связи с преобразованием клеток пигментного эпителия является подтверждением трансформационной теории, а отложение клеток измененного пигментного эпителия — депозитной теории.
Дальнейшее развитие друз приводит либо к развитию неэкссудативной предисциформной макулодистрофии либо ее экссудативной дисциформной формы с хороидальной или субретинальной неоваскуляризацией. Эти превращения происходят позднее, в пятой-шестой декадах жизни, при этом твердые друзы способствуют развитию атрофических изменений, мягкие же сливные друзы, особенно расположенные билатерально, приводят к экссудативной отслойке пигментного эпителия и другим осложнениям, определяющим дальнейшее прогрессирование процесса.
Доминантные друзы мембраны Бруха представляют собой важный аспект в офтальмологии, вызывая интерес у специалистов. Врачи отмечают, что наличие таких друз может быть связано с возрастными изменениями и предрасположенностью к различным заболеваниям сетчатки. Многие эксперты подчеркивают, что ранняя диагностика и мониторинг состояния мембраны Бруха имеют ключевое значение для предотвращения серьезных осложнений, таких как возрастная макулярная дегенерация. Врачи рекомендуют регулярные осмотры у офтальмолога, особенно для пациентов старше 50 лет, чтобы своевременно выявить изменения и начать необходимое лечение. Таким образом, внимание к доминантным друзам мембраны Бруха становится важным элементом в стратегии сохранения зрения.

Клиническая картина
Вначале это маленькие круглые пятна, светлее окружающего их фона глазного дна, со временем приобретающие яркий желтый цвет. По мнению D.A. Newsome (1988), первая их диагностика возможна скорее ангиографически, чем офтальмоскопически. Авторы настоящей главы не разделяют эту точку зрения. Считается, что друзы, локализующиеся кнутри от диска зрительного нерва, или множественные, покрывающие почти все глазное дно, являются доминантными друзами. Как правило, их обнаруживают в центральной зоне и на средней периферии. В редких случаях друзы могут наблюдаться только на средней периферии и отсутствовать в центре. Возможно периферическое расположение друз, иногда с сетевидным пигментом, в связи с чем они напоминают ретикулярную дистрофию Сьегрена или «гроздь винограда».
Со временем размер и количество друз увеличиваются, они сливаются, кальцифицируются, приподнимают сенсорную сетчатку. В очень редких случаях количество друз может уменьшаться. Заметные изменения происходят и в пигментном эпителии, покрывающем друзы. Он истончается, теряет пигмент, появляются скопления пигмента вокруг друз. Эти изменения пигментного эпителия наблюдаются в макуле между друзами и могут приводить к атрофии клеток пигментного эпителия.
S.H. Sarks и соавт. (1996) выделяют два основных типа друз — мягкие и твердые. Твердые друзы — маленькие, множественные, гиалинизированные, имеют крошковидную форму, часто кальцифицированные, как правило, не сливаются. В мягких друзах происходит разрушение гиалинового материала. Обычно они более крупные и имеют тенденцию к слиянию.
Друзы могут располагаться над и под базальной мембраной пигментного эпителия, иногда их находят и в хороикапиллярном слое. Как правило, друзы являются офтальмоскопической находкой, так как протекают бессимптомно, даже если локализуются в фовеа, в редких случаях больные жалуются на метаморфопсию. Острота зрения не снижается, дефектов в поле зрения не бывает.
Во время флюоресцентной ангиографии друзы начинают флюоресцировать в ранних фазах с постепенно нарастающей интенсивностью, которая в позднюю венозную фазу быстро снижается. Обычно ангиографически выявляют значительно большее число друз, чем при офтальмоскопии. Твердые друзы, даже в местах их скопления и кажущегося слияния, на ФАГ видны в виде отдельных гиперфлюоресцирующих точек. В редких случаях на флюоресцентных ангиограммах наблюдается гипофлюоресценция друз, обусловленная их кальцификацией или пигментацией.
Доминантные друзы мембраны Бруха вызывают активные обсуждения среди специалистов в области офтальмологии и пациентов. Многие отмечают, что эти образования могут быть признаком различных заболеваний, включая возрастные изменения сетчатки. Некоторые пациенты выражают беспокойство по поводу возможного влияния друз на зрение, хотя многие исследования показывают, что в большинстве случаев они не приводят к значительным нарушениям. В то же время, врачи подчеркивают важность регулярных осмотров, чтобы отслеживать изменения в состоянии глаз. Обсуждения в медицинских кругах также касаются методов диагностики и лечения, что свидетельствует о необходимости дальнейших исследований в этой области. В целом, мнения о доминантных друзах варьируются, но все согласны в одном: внимание к здоровью глаз — залог хорошего зрения.
Дифференциальная диагностика
Друзы следует дифференцировать от ряда заболеваний, характеризующихся желтоватыми или беловатыми отложениями в заднем полюсе глаза, которые вместе с наследственными друзами отнесены А.Е. Krill (1977) к синдрому «flecked retina»:
- fundus punctatus albescens — белоточечная абиотрофия глазного дна при которой определяются белые очажки, похожие на друзы, на средней периферии глазного дна. Это заболевание характеризуется резким снижением зрения и прогрессирующей никталопией, сходной с ранними и легкими формами пигментной абиотрофии сетчатки.
- fundus albipunctatus, или белоточечное глазное дно, двусторонняя наследственная патология,по офтальмоскопической картине сходная и с предыдущим заболеванием, и с наследственными друзами, но отличающаяся от них непрогрессирующим течением и стационарным характером ночной слепоты, протекает без снижения зрения.
При офтальмоскопическом исследовании на уровне пигментного эпителия видны беловатые точечные одинаковые по форме округлые пятна, занимающие большую площадь глазного дна с максимальной плотностью в экваториальной и макулярной областях. В отличие от fundus albipunctatus доминантные друзы более вариабельны по размеру и больше проминируют в макулярной области.
fundus flavimaculatus, или желтопятнистое глазное дно, двустороннее заболевание, которое в отличие от ровных, круглых, с четкими границами доминантных друз характеризуется желтоватыми отложениями на уровне пигментного эпителия в виде пятен.
При ангиографии часто выявляют блокаду хороидальной флюоресценции в заднем поле и на периферии, которая никогда не наблюдается при доминантных наследственных друзах. Другим отличием fundus flavimaculatus является частое сочетание ее с макулярной дистрофией по типу «бычий глаз», которая никогда не встречается при наследственных друзах. Острота зрения снижается при сочетании этой патологии с болезнью Штаргардта. Для fundus flavimaculatus характерно сужение поля зрения, чего не бывает при друзах.
- дистрофия Биетти, или кристаллиновая дистрофия, которой также свойственны беловатые отложения на сетчатке, но в отличие от доминантных друз, они имеют полигональную форму с «бриллиантово-белым» блеском и локализуются во всех слоях сетчатки. Заболевание характеризуется прогрессирующим снижением зрительных функций и краевой дистрофией роговицы.

Вопрос-ответ
Что такое друзы мембраны Бруха?
Друзы – отложения аморфного материала между базальной мембраной пигментного эпителия сетчатки (ПЭС) и внутренним коллагеновым слоем мембраны Бруха. Депозиты могут локализоваться как в области желтого пятна, так и вне макулярной области.

Как лечить друзы сетчатки глаз?
В качестве лечения друзы сетчатки глаза назначается пороговая лазеркоагуляция. Большие мягкие макулярные друзы при этом регрессируют в 88,9% случаев. Толщина нейросенсорной сетчатки увеличивается, улучшается ее светочувствительность.
Какой основной компонент друз?
Основным признаком такой болезни является образование друз в сетчатке, основой которых является липофуксин. Друзы представляют собой крошечные округлые плотные беловато-желтые образования.
Советы
СОВЕТ №1
Регулярно проходите обследования у офтальмолога, особенно если у вас есть предрасположенность к заболеваниям глаз. Это поможет выявить доминантные друзы мембраны Бруха на ранних стадиях и предотвратить возможные осложнения.
СОВЕТ №2
Обратите внимание на свое питание. Включение в рацион продуктов, богатых антиоксидантами (таких как шпинат, морковь и ягоды), может помочь поддерживать здоровье глаз и замедлить прогрессирование заболеваний сетчатки.
СОВЕТ №3
Избегайте чрезмерного воздействия ультрафиолетового излучения. Носите солнцезащитные очки с высоким уровнем защиты, чтобы снизить риск повреждения глаз и ухудшения состояния мембраны Бруха.
СОВЕТ №4
Следите за состоянием своего общего здоровья. Хронические заболевания, такие как диабет и гипертония, могут негативно влиять на здоровье глаз, поэтому важно контролировать их и соблюдать рекомендации врача.
fundus flavimaculatus, или желтопятнистое глазное дно, двустороннее заболевание, которое в отличие от ровных, круглых, с четкими границами доминантных друз характеризуется желтоватыми отложениями на уровне пигментного эпителия в виде пятен.